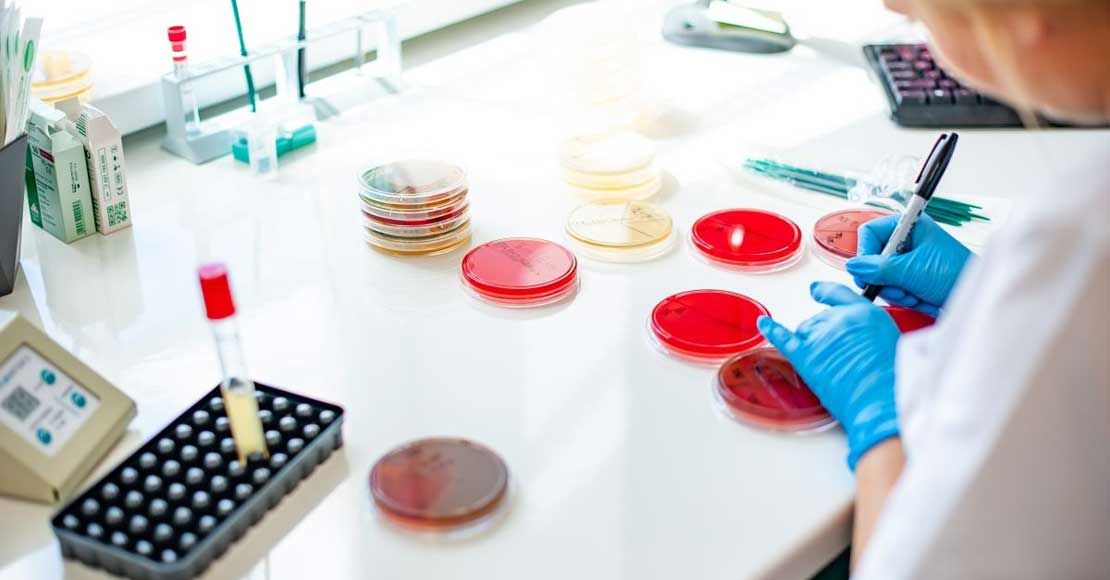

Akcja profilaktyczna w Obornikach i Rogoźnie
W punktach pobrań Diagnostyki Laboratoriów Medycznych w Obornikach i Rogoźnie w ramach specjalnej akcji profilaktycznej będzie można wykonać szereg badań w specjalnie obniżonych cenach. Akcja potrwa do końca wakacji 2023 roku.
W wakacje zatroszcz się o siebie
Badania gruczołów: tarczycy u kobiet i gruczołu krokowego u mężczyzn to bardzo ważna część profilaktyki zdrowotnej. TSH u kobiet monitoruje funkcje tarczycy, a PSA u mężczyzn pozwala mieć pod kontrolą prostatę. W specjalnej, obniżonej do 25 zł cenie wykonamy te badania w Obornikach w jednym z dwóch punktów Diagnostyki: przy ul. Piłsudskiego 62
i w Rynku 12 oraz w Rogoźnie przy ul. Wojska Polskiego 4a. Dodatkowo w Rogoźnie większość badań podstawowych została objęta 20% rabatem, a morfologia kosztuje 2 zł.
Diagnostykę chorób tarczycy rozpoczyna się od pomiaru stężenia TSH – hormonu przysadkowego nadzorującego pracę gruczołu. Jest to najczulsze badanie oceniające pracę gruczołu, wykrywające objawowe jak i bezobjawowe zaburzenia czynności tarczycy. Obserwowane zmiany w stężeniu TSH wyprzedzają w czasie zmianę stężenia hormonów produkowanych przez samą tarczycę, a charakter tych zmian pozwala na rozpoznanie nadczynności lub niedoczynności gruczołu. Zaburzenia te wpływają na nasz metabolizm (odpowiednio utrata lub przybieranie na wadze), powodują tzw. suchą skórę lub nadpotliwość, zaparcia lub biegunki, wpływają na płodność, a nawet równowagę emocjonalną.
Jeśli chodzi o PSA, to nie ma bardziej specyficznego, męskiego badania. Służy ono do monitorowania działania gruczołu prostaty, oznaczanie PSA w surowicy zrewolucjonizowało rozpoznawanie raka gruczołu krokowego – jego podwyższone wartości powinny być powodem do wizyty u lekarza. Co prawda z wiekiem stężenie tego znacznika wzrasta, jednak każdą anomalię warto skonsultować z lekarzem.
Morfologia krwi jest badaniem, które pozwala ocenić ogólną kondycję organizmu oraz wnosi wiele istotnych informacji na temat niedoborów pierwiastków lub witamin będących przyczyną anemii oraz etiologii toczących się infekcji. Pozwala także na wykluczenie choroby nowotworowej układu krwiotwórczego lub zaburzeń odporności, także przy każdej wizycie w laboratorium warto je wykonywać. Dodatkowo z cennika Diagnostyki możemy wybrać kilkadziesiąt badań i w Rogoźnie zrealizować je z 20% rabatem. Nie jest potrzebne skierowanie.
Aby skorzystać z akcji profilaktycznych wystarczy udać się do jednego z trzech punktów pobrań (Oborniki, ul. Piłsudskiego 62, Rynek 12 i Rogoźno, ul. Wojska Polskiego 4a) podając jako źródło informacji nasz portal.













